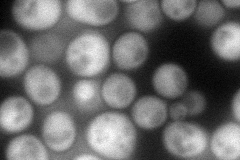
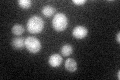

View description
Putative ribokinase
Localization:
Intensity:
Fold change:
Significance:
-
C’ GFP library in SD

cytosol34.53 -
N' NOP1pr-GFP in SD
cytosol140.78 -
N' TEF2pr-mCherry in SD

cytosol19.5379 -
N' NATIVEpr-GFP in SD

cytosol34.5171 -
N' TEF2pr-VC and Cyto-VN in SD

cytosol54.1868 -
C’ GFP library in SD+DTT

cytosol51.051.47Yes -
C’ GFP library in SD+H2O2

cytosol54.021.56Yes -
C’ GFP library in Starvation Media
cytosol69.081.99Yes -
C’ GFP library on the background of Pup2-DaMP

cytosol -
C’ GFP library on the background of CCT mutant

cytosol38.59041.11719No
